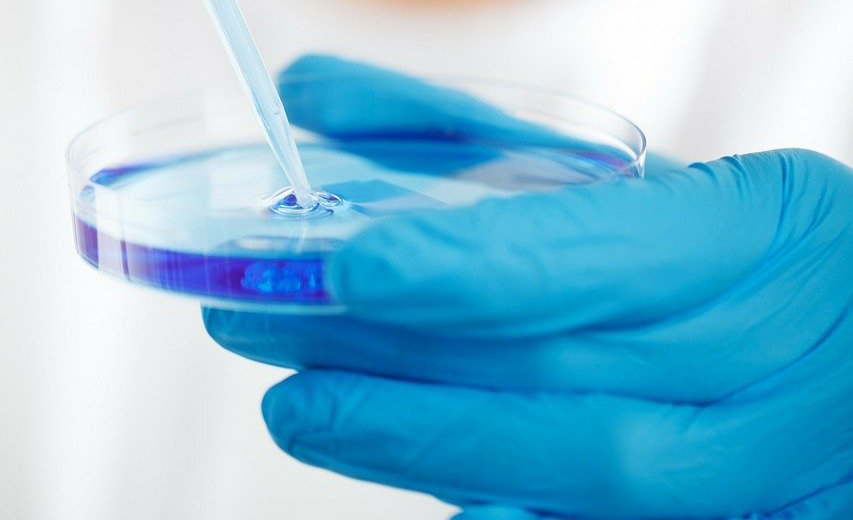
cat 3

Унитарное предприятие "Витебский зооветснаб" предлагает
-
АНТИБАКТЕРИАЛЬНЫЕ ПРЕПАРАТЫ (ИНЪЕКЦИОННЫЕ И ПОРОШКИ)

-
ПРОТИВОПАРАЗИТАРНЫЕ ПРЕПАРАТЫ

-
ПРОТИВОМАСТИТНЫЕ, ГОРМОНАЛЬНЫЕ И ГИНЕКОЛОГИЧЕСКИЕ ПРЕПАРАТЫ
-
МАЗИ, НАСТОЙКИ, РАСТВОРЫ, ПРЕПАРАТЫ, СОДЕРЖАЩИЕ ВИТАМИНЫ, МИКРО- И МАКРОЭЛЕМЕНТЫ

-
ВАКЦИНЫ И СЫВОРОТКИ ДЛЯ ЖИВОТНЫХ

-
ВЕТЕРИНАРНЫЙ ИНСТРУМЕНТАРИЙ, ХОЗИНВЕНТАРЬ, СПЕЦОДЕЖДА И ОБУВЬ, ЖУРНАЛЫ УЧЁТА

-
РАСХОДНЫЕ МАТЕРИАЛЫ ДЛЯ МОЛОЧНОГО ОБОРУДОВАНИЯ

-
ДЕЗИНФИЦИРУЮЩИЕ, ИНСЕКТОАКАРИЦИДНЫЕ И РОДЕНТИЦИДНЫЕ СРЕДСТВА

Консультация по препаратам
Специалисты предприятия с радостью ответят на ваши вопросы, произведут расчет стоимости препаратов и подготовят индивидуальное коммерческое предложение.
О компании


Снабженческо-производственное унитарное предприятие «Витебский зооветснаб» - известный поставщик ветеринарных препаратов на рынке Республики Беларусь.
Предприятие осуществляет оптовую и розничную торговлю ветеринарными и биологическими препаратами, витаминами и кормовыми добавками, зоотехническими товарами, доильным оборудованием, спецодеждой, дезинфицирующими и моющими средствами.
Наше предприятие сотрудничает с ведущими белорусскими производителями, которые зарекомендовали себя на рынке. Гарантируем качество и надежность препаратов!
В ассортименте всегда большой выбор препаратов белорусских, российских и зарубежных производителей.
Многолетний опыт позволяет давать нашим покупателям полезные рекомендации с учетом их потребностей. Мы помогаем подобрать оптимальные медикаменты для сельскохозяйственных животных (крупных и мелких пород), в том числе для кроликов, лошадей, коров, птиц, а также лекарства для кошек и собак.
Снабженческо-производственное унитарное предприятие «Витебский зооветснаб» представлено сетью ветеринарных аптек, которые расположены в г. Витебске, г. п. Бешенковичи, г. Орша, г. п. Лиозно, г. Толочине, г. Чашники.
Снабженческо-производственное унитарное предприятие «Витебский зооветснаб» поможет позаботиться о здоровье Ваших животных!
